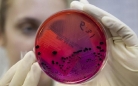

В Карагандинской области лабораторная экспертиза подтвердила диагноз «сибирская язва» у всех троих человек, госпитализированных в медучреждения с подозрением на особо опасную инфекцию. Об этом сообщила пресс-служба акима области.
«Двое пациентов, жители зимовки Ушарал (Каппарова А., Байжуманов Д.) находятся в КГП «Областная инфекционная больница». Третий больной, житель города Балхаш (Жылкайдаров Д.) находится в центральной больнице Балхаша. У всех троих диагноз сибирской язвы подтвержден лабораторными исследованиями», - говорится в сообщении.
Выявлено, что больные 16 августа участвовали в вынужденном забое бычка из своего подворья. Мясо было продано перекупщикам. В настоящее время остатки мяса в количестве 70 кг изъяты и уничтожены. За контактными лицами установлено ежедневное медицинское наблюдение с проведением профилактического лечения.
«Источником инфекции послужило забитое без ветеринарного осмотра и реализованное по подложным ветеринарным документам не вакцинированное животное. Хозяин животного заразился контактным путем при разделке сырого мяса», - сообщила пресс-служба акима области.
Ранее Комитет по защите прав потребителей информировал об одном подтвержденном случае в Актогайском районе.
«С момента получения сигнала о госпитализации двух жителей зимовки Ушарал сельского округа Жидебай Актогайского района с подозрением на сибирскую язву, были приняты все меры для защиты населения и локализации инфекции, согласно утвержденному Комплексному плану противоэпидемических мероприятий по санитарной охране территории области от возникновения, завоза и распространения карантинных и особо опасных инфекций», - отмечено в сообщении.
Были оповещены все заинтересованные государственные органы министерств сельского хозяйства, здравоохранения и социального развития, национальной экономики и другие.
«Организована работа в режиме ЧС, выставили полицейские посты, исключили перемещение животных и всей продукции животного происхождения», - добавили в пресс-службе акима области.
Подчеркивается, что специалисты ветеринарной и санитарной служб работают в очаге круглосуточно, проводят ежедневные подворовые обходы. По информации пресс-службы акима области, в крестьянском хозяйстве «Женис» объявили карантин.
Кроме того, во всех близлежащих населенных пунктах провели сход с населением. Сельчанам выдали предупреждения о запрете убоя скота без предварительного осмотра ветврачей.
«Ситуация находится под особым контролем», - заверили в областном акимате.
Напомним, 26 августа в областную инфекционную больницу госпитализировали двух жителей аула Ушарал сельского округа Жигебай Актогайского района с подозрением на сибирскую язву. Мужчина и женщина 1972 г.р. являются супругами. Позже сообщили о госпитализации в больницу Балхаша парня, работающего рубщиком мяса.
В июне в селе Еркиндик Шетского района Карагандинской области произошла вспышка сибирской язвы. Установлено, что сельчанин зарезал больную сибирской язвой корову и раздал мясо родственникам и соседям. В селе вводился карантин. В областную инфекционную больницу с подозрением на сибирскую язву госпитализировали 11 человек. Лабораторно подтвердилось 8 случаев. Двое заболевших скончались - 33-летняя женщина и 49-летний мужчина.
Валентина Елизарова